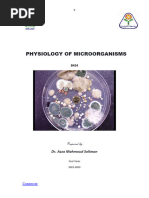

100% found this document useful (1 vote)
1K views22 pagesMicrobial Growth
This document summarizes principles of bacterial growth, including definitions of growth, the process of binary fission, generation time, growth curves, nutritional and environmental factors that affect growth, and methods used to study bacterial growth in the laboratory. Key points covered include temperature and oxygen requirements of different bacterial groups, pH tolerance, and the effects of water availability. Measurement of growth and common culture techniques are also outlined.
Uploaded by
KunjalCopyright
© Attribution Non-Commercial (BY-NC)
We take content rights seriously. If you suspect this is your content, claim it here.
Available Formats
Download as PDF, TXT or read online on Scribd
100% found this document useful (1 vote)
1K views22 pagesMicrobial Growth
This document summarizes principles of bacterial growth, including definitions of growth, the process of binary fission, generation time, growth curves, nutritional and environmental factors that affect growth, and methods used to study bacterial growth in the laboratory. Key points covered include temperature and oxygen requirements of different bacterial groups, pH tolerance, and the effects of water availability. Measurement of growth and common culture techniques are also outlined.
Uploaded by
KunjalCopyright
© Attribution Non-Commercial (BY-NC)
We take content rights seriously. If you suspect this is your content, claim it here.
Available Formats
Download as PDF, TXT or read online on Scribd